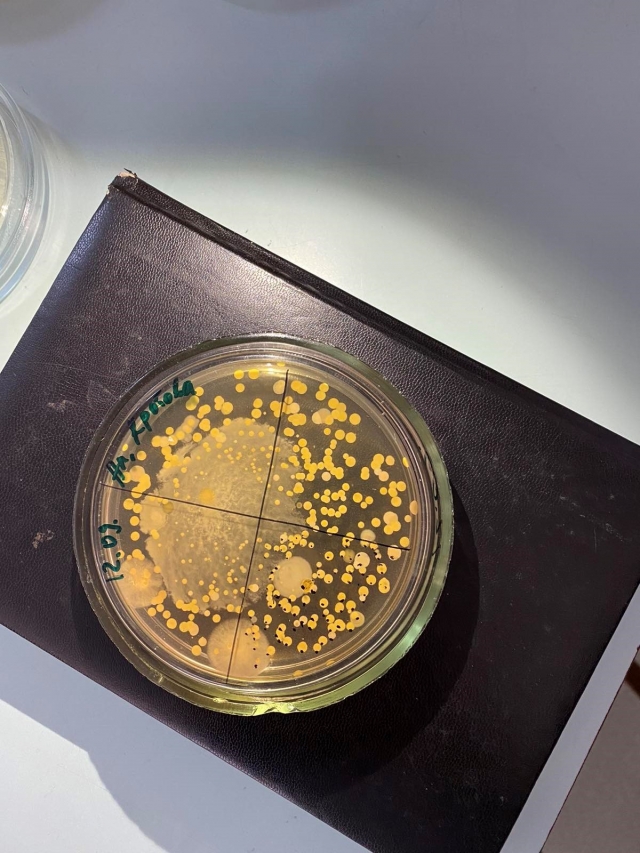

Діяльність студентського наукового гуртка «Санітарна і харчова мікробіологія»
У формуванні лікарського мислення, професійних навичок та практичної діяльності у студентів факультету ветеринарної медицини важливого значення набуває додаткова робота у студентському науковому гуртку «Санітарна і харчова мікробіологія», що функціонує на кафедрі епізоотології, мікробіології і вірусології вже протягом 10 років.
Робота студентського наукового гуртка «Санітарна і харчова мікробіологія» спрямована на залучення студентів у науково-дослідну та інноваційну діяльність, популяризацію науки, встановлення та підтримку зв'язків з гуртківцями інших навчальних закладів вищої освіти.


Щороку гурток поповнюється новими студентами, які прагнуть працювати в лабораторії за інтересами, в напрямку дослідження мікрофлори об’єктів зовнішнього середовища, тваринницької сировини і готових харчових продуктів.
Так і цього навчального року студентами-гуртківцями були проведені мікробіологічні дослідження різних матеріалів, зокрема курятини, свинини, питної води, ґрунту.

Досліджено мікробіологічну безпечність повітря навчальних аудиторій за використання аспіраційного та седиментаційного методів.
Також були проведені онлайн засідання гуртка «Санітарна і харчова мікробіологія», на яких обговорювалися актуальні збудники харчових отруєнь, зокрема Campylobacter, Salmonella, Yersinia, E. coli (STEC), Listeria.
За результатами виконаних досліджень планується підготовка матеріалів для участі у студентських конференціях.
Керівник гуртка, доцент Ганна Козловська